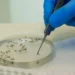
Opas faz alerta sobre possível transmissão do vírus oropouche da mãe para o bebê

Na manhã desta sexta-feira (19), a Polícia Rodoviária Federal (PRF) atuou em conjunto com o Ministério Público Estadual na “Operação Ceres”, que investiga um esquema de propina envolvendo servidores e ex-funcionários do Instituto de Meio Ambiente e Recursos Hídricos (Inema). A operação foi conduzida pelo Grupo de Atuação de Combate às Organizações Criminosas e Investigações Criminais (GAECO) e pela Promotoria de Justiça de Proteção da Moralidade Administrativa, com apoio adicional da Cipe Sudoeste e do Comando de Policiamento Regional do Extremo Sul da Bahia, da Polícia Militar.

As investigações sugerem que seis pessoas, entre servidores e ex-funcionários do Inema, estão envolvidas em crimes de corrupção ativa e passiva, lavagem de dinheiro e associação criminosa. Segundo os promotores, essas pessoas teriam recebido aproximadamente R$ 16,5 milhões em propinas de fazendeiros do oeste da Bahia, para facilitar ilegalmente a concessão de licenças ambientais e autorizações de supressão de vegetação entre 2019 e 2023.
O pagamento das propinas era feito principalmente por fazendeiros e empresas ligadas a empreendimentos rurais, através de depósitos bancários nas contas de um dos investigados. Durante a operação, foram cumpridos sete mandados de busca e apreensão em residências localizadas em Salvador, Camaçari, Guanambi e Riacho de Santana, além de uma empresa em Lauro de Freitas. A Justiça também determinou a suspensão das funções de um técnico do Inema e o sequestro de bens dos envolvidos.

Os materiais apreendidos, incluindo documentos, celulares, computadores e joias, serão analisados pelos promotores de Justiça e encaminhados aos órgãos competentes para as medidas cabíveis. Na mitologia romana, Ceres é a deusa da agricultura e da fecundidade da terra, nome que simboliza a operação.